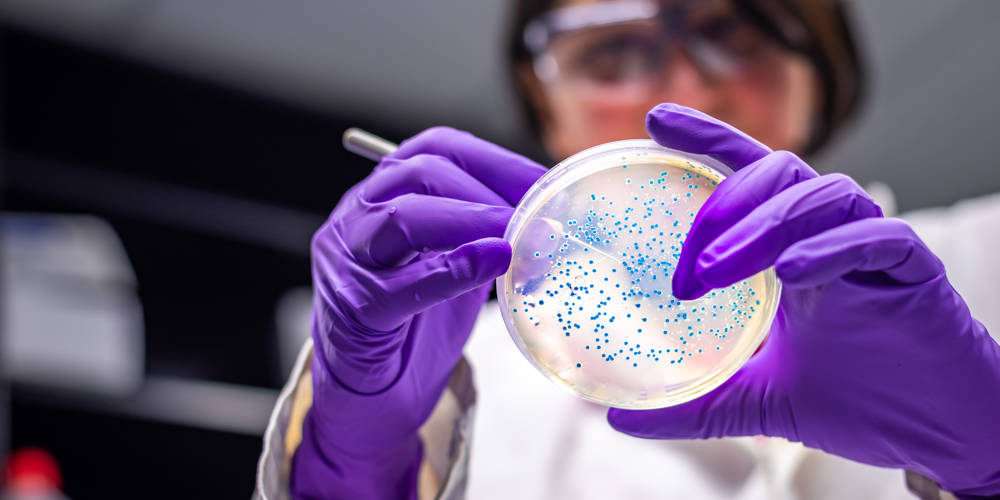
Istock 1131003688 Istock 1131003688

The Qualified Person (QP) needs to understand the significance of the presence of bacteria, yeasts, moulds, viruses and toxins in pharmaceutical raw materials, intermediates, products and production environments. In addition, the need for a good understanding of the microbiological control of pharmaceutical products, production environments and people is also a necessity.
This course will cover the main types and sources of micro-organisms and the issues associated with both sterile and non-sterile pharmaceutical production. Specific sessions will cover water systems, clean room design and operation, the concept of sterilisation and sterility assurance.
The classroom version of this course includes a microbiology practical session on the third day, run at RSSL's microbiology and sterility laboratory in Wokingham.
SPECIAL OFFER - If you book our Introduction to Pharmaceutical Microbiology course, you will receive a discount of £350 off this course (excludes Trainee QPs on packages).
Interested in QP training for your team? Contact us today.

This course is one of a series of modules designed specifically to satisfy the requirements of the QP Study Guide. It is a popular module for trainee QPs who are non-microbiologists. It will also be of benefit to other Quality professionals, production technologists and these working in support functions. In addition, this module produces an ideal opportunity for those who need to ensure they carry out Continuing Professional Development (CPD).

The course includes the following topics:

Microbiology, Microorganisms and QP Study Guide

Ecology and significance of microbes

Contamination control

Manufacture of sterile products in clean rooms

Water microbiology

Sterilisation principles and assurance

Sterilisation processes and depyrogenation

Disinfection and sporicidal agents

Testing - Environmental Monitoring (EM)

Cherwell demonstration

EM limit setting

Media fills

Control of media, reagents and equipment

MLT, specified organisms and water testing

Sterility testing

Rapid enumeration methods of testing

Microorganism identification

Endotoxins and pyrogens

Laboratory session includes laboratory safety, MLTs, gram staining finger dabs and swabs

Water activity testing

Antimicrobial efficacy testing

Biological assays

Failure investigation and OOS
At the end of the course you will:

Understand the sources and types of microorganisms relevant to pharmaceutical production operations

Understand the microbiological controls required for both sterile and non-sterile products

Appreciate the microbiology of water, its production and distribution systems

Appreciate test methods often used and the interpretation of microbiological data


| Yes, QP Trainee packages are available with RSSL and include a number of exclusive benefits. Contact our QP Training Advisor to learn more on trainingsales@rssl.com or by calling +44 (0)118 918 4000, and join our upcoming webinar, 'To QP or not to QP?', designed for aspiring QPs. |
| Places will be available for you to book unless it states ‘Full’ next to your chosen QP Pharmaceutical Microbiology course date. When this occurs, we operate a waiting list service. |
| Yes, we welcome bookings from self-funding individuals. Once your booking has come through to us, we will ask you to complete a new customer form and provide a scanned copy of your photographic ID so that we can raise an account for you on our systems. |
| You will need to first register yourself on our booking system by selecting the QP Pharmaceutical Microbiology course date that you wish to book your colleagues onto, then: - Add the number of people you wish to book onto the course - Register yourself as the booker and complete the fields accordingly - Add the details of those you wish to book for - Complete your order. |
| You will receive an automated email confirming your booking details for the QP Pharmaceutical Microbiology course. 10 days before the start date, if the course is confirmed to run, you will receive another email including the final course details. If the course is to be held virtually, the online registration and joining instructions will also be included. |
Yes, this three day QP Pharmaceutical Microbiology course is available in-person or virtually on the Adobe Connect training platform. If a venue is listed against your preferred course date, then this course is scheduled as an in-person session.
When online, this course begins at 08:45am, although we request that you login at 08:30am for registration. For our in-person courses, refreshments are available from 08.30am, for a 08:45am start. The standard finish time is 17:00pm, though some courses will finish slightly earlier or later.
Please review your course confirmation email to double check the exact start time of your specific course. If you need an exact finishing time to allow for travel arrangements, please contact us via trainingsales@rssl.com or +44 (0)118 918 4000.
| Your invoice will be sent approximately 30 days prior to the course start date. If you are a new customer to RSSL, shortly after we receive your booking, you will be asked to complete a New Customer Form so that an account can be created for you on our finance system. |
| Yes, companies wishing to book multiple employees on one of our standard training courses (excluding IRCA Lead Auditor courses) can benefit from our group booking discount. This discount is only applicable to bookings made for the same course on the same date. Please contact trainingsales@rssl.com with your requirements and we will be happy to provide more information on the best deal available for you. |
| Yes, we offer NHS Trusts a 20% discount on ALL our courses, including our Qualified Person training programme. When booking your course/s enter 'NHS' in the discount code field so that your discount can be applied on your invoice. Please note that the NHS discount code is only valid when the booker uses a NHS email address. |
| Yes, certificates of attendance are issued after we have received payment in full for the course. If you have not received your certificate, please contact your own finance department to confirm if they have sent payment to us. All certificates are issued electronically by email. |
| Our classroom courses are fully catered, and we provide all refreshments. If you have any special dietary requirements, please enter these into the ‘dietary requirements’ field when creating your account. Our virtual tutor-led courses will include a 45-minute lunch break. |
Discover the feedback from our course alumni and learn why they chose RSSL to support their professional development.
We offer bespoke in-house training solutions to you and your organisation. Contact an expert today to talk about your team and your specific requirements.
We offer a number of discounts and specials offers on our training courses including Group booking, NHS and Seasonal discounts.
As scientists ourselves, we’re passionate about collaboration and sharing our expertise to nurture the next generation. By helping them to develop and fulfil their potential, we can tackle 21st-century pharmaceutical scientific challenges more effectively.

More than 30 years of experience upskilling pharmaceutical professionals

Small-group training adjusted to individual learning styles and needs

50+ training courses accredited by recognised industry bodies

Combination of off-the-shelf and bespoke training packages

Courses and consulting led by experts in the entire pharmaceutical life cycle

Opportunity to share and learn as part of a diverse community